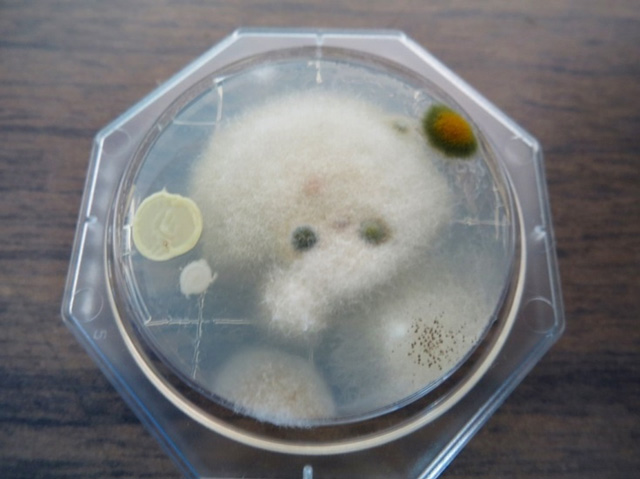
カビイメージ

FRS工法《カビ根絶の新工法》
落としきれなかったカビを根元から除去!!
FRS工法は、ハウスクリーニングと異なり、カビ(真菌)や菌類を根元から死滅させ除去し、これに加えて防カビ処理を行い、長期間のカビ(真菌)の発生を防止する工法です。
施工前

施工後

FRS工法の特徴
こすらず根元からカビを根絶!
カビの殺菌剤や漂白剤を使って、ブラシなどでこすり落とす方法ではありません。壁や木材等の材料内部に特殊洗剤を浸透させて洗浄剤の力でカビ(真菌)の核を分解し、元から除去する方法です。
大掛かりな機材は使用しません!
リフォーム工事のような解体作業などは行いません。
環境にやさしく安全!
特殊洗剤の成分は、食品添加物に使用されているものと同じ成分を使用していますので、人体や動植物にも安心で、しかも環境にも優しい洗浄剤です。
施工対象
コンクリート、タイル、サイディング、石材、クロス、墓石など多種多様な材料に対応できますが、施工できない材質もございますので、まずはご相談ください。
浴室の天井や壁のカビ落とし
施工前

施工後

シャワーホースのカビ落とし
施工前

施工後

浴室の天井や壁のカビ落とし
施工前

施工後

あきらめていたカビを根絶!FRS工法
- お風呂のカビ汚れが落ちない
- いくらこすっても消えない汚れがある
- 外壁のカビが気になるけど自分ではできない
- カビによる身体の影響が気になる。
1つでもチェックが付く方はFRS工法でそのお困り事が解決できるかもしれません!!
施工前

施工後

このような目に見えるカビの場合、1㎠あたり約40億個の真菌(カビ)が底に潜んでいることになります。
カビのメカニズム
カビ(真菌)は本来土壌の中で他の微生物と共存し、植物などに寄生していますが、成長すると胞子を空気中に飛散させ、塵や水蒸気などに付着して空気中を移動し、あらゆる物に付着して増殖します。
このカビ(真菌)の胞子を人間が吸い込むことにより、アレルギー性疾患の抗原体(アレルゲン)となって、気管支炎やアトピー性皮膚炎、花粉症、鼻炎などを引き起こします。
ちなみにお風呂のタイル目地に発生する黒カビは1c㎡あたり40億個の胞子を持っているといわれています。
ペニシリウム属

特徴
一般に建築物の塗装面によく生え乾燥に強く発育はやや遅い。
人体への影響
アオカビとも呼ばれ、腎毒性の強いカビ毒で食中毒になる。
アルテルナリア属

特徴
ススカビとも呼ばれ、灰色・黒色。好湿性のカビ。種々の食品、土壌、空気中などの生活環境に広く存在している。
人体への影響
喘息、アレルギーの原因になる。
クラドスポリウム属

特徴
ビニルクロスやタイルの目地・壁面によく検出される黒色の真菌で、温度の高い条件でよく発育する。
人体への影響
喘息、アレルギーの原因になる。
アスペルギルス属

特徴
一般に果物や野菜、パンなどにもよく生える黒かびもその1種
人体への影響
被害は劣化、汚染、アレルゲン、真菌感染症などがある。この菌による死亡は熱帯地方でよく発生している。
カビが見えるという事は・・・
カビ(真菌)は胞子の状態で空気中を浮遊し、カビの好む環境(高栄養・高湿度)を見つけ、コロニー(集落)を形成します。カビの胞子自体の大きさは2~10μm(マイクロメートル)で多くは肉眼では見えません。カビが肉眼で確認できるという事はカビがコロニー(集落)を形成した状態であり、黒くなったようなカビの巣になると1c㎡あたりのカビの胞子数は10~15億個におよびます。またお風呂場のタイルの目地に黒くなっているカビは、1c㎡あたり40億個の胞子を持っているといわれています。
FRS工法はこれらの健康に悪影響を及ぼしかねないカビ(真菌)を確実に分解・殺菌し、またその成果をルミテスターと呼ばれる検査機器を用いて数値化することによりお客様に心から納得していただける工法です。
また何故カビが繁殖したかの原因を探し、カビが生えにくい環境づくりのアドバイスもさせて頂きます。
カビを調査・研究し、衛生的な環境をつくる
Fungus Research Sanitation
ファンガス・リサーチ・サニテーション(真菌(カビ) ・ 研究 ・ 衛生)
目に見える汚れだけでなく、見えない汚れ・病原性・微生物まで分解させ衛生的な環境を作り上げるのがFRS工法です。
施工の流れ
- ご訪問・パッチテスト
ルミテスター現場の状況を確認させていただき、ルミテスター(写真)を使ってATPふき取り検査を行います。
また、目立たない箇所でパッチテスト(薬剤を部分的に塗布して効果を確認)をさせて頂きます。
※ ATPふき取り検査とは、すべての生物の細胞内に存在するATPの量を測定し、測定箇所にどれだけの微生物やその栄養源となる物質が存在しているかを数値化する検査方法です。を防止する工法です。 - お見積りの提出
- お見積提出
- 本施工
お見積もりにご納得いただければ本施工となります。施工後にもルミテスターでの検査を行いますので、汚れの落ち具合が見た目だけでなく数値として理解できるので安心です。 - お引渡し
Contact
リフォームのことならなんでも、創造工舎にお気軽にお問い合わせください。
LINK










